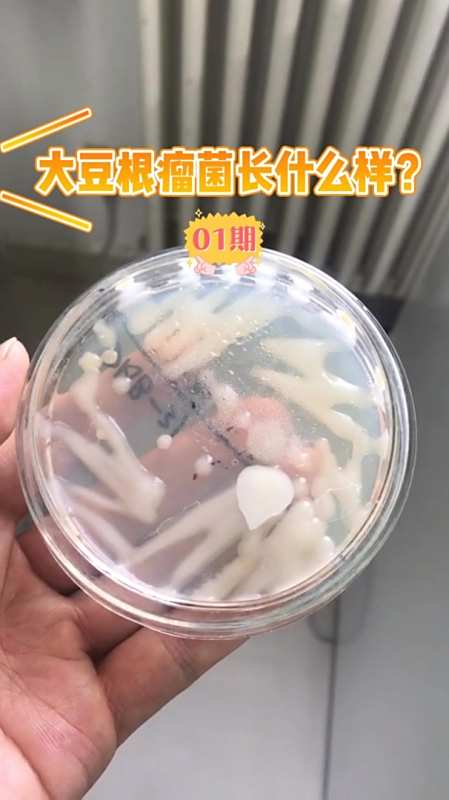
大豆根瘤菌长什么样一起来认识认识吧

根瘤菌胡桃

胡桃摇摆-二(根瘤菌rkzj)
图片尺寸406x228
桃树常见病之根瘤病症状及防治方法
图片尺寸640x392
竞争性杂菌:胡桃肉状菌
图片尺寸500x360
为什么豆科植物能与根瘤菌共生固氮?中国科学家破解百年难题
图片尺寸1920x1920
这种桃树根上长得野蘑菇能吃嘛?
图片尺寸720x1280
严重不严重?大家看图文!#多肉植物 #根瘤菌 - 抖音
图片尺寸864x1920
根瘤菌
图片尺寸1200x803
什么是根瘤菌?买花要看仔细,根系上带着"凸起",极其难养
图片尺寸580x773
这是根瘤菌吗?怎样治疗?
图片尺寸886x1920
请问这是什么菌类,从桃树接近根部摘的,内圈是有层木质
图片尺寸600x800
什么是根瘤菌是好还是坏根系上带着凸起应该怎么处理
图片尺寸582x418
豆科植物中的根瘤菌与宿主是怎样形成共生关系的?
图片尺寸450x423
陇黄大豆和大豆根瘤菌相继冲上太空香港首个于太空进行空间搭载实验的
图片尺寸1080x608
花生根系分布与根瘤菌固氮能力
图片尺寸1280x1696
长在核桃树根上,听说是鸡蛋菌可以吃,真的可以吃吗?
图片尺寸390x520
樱花94常见的根瘤菌.苗圃现状 樱花栽植前土壤,根部杀菌极为 - 抖音
图片尺寸1440x1920
能不能吃呀?
图片尺寸1280x956
豆科植物根瘤菌是如何固氮的
图片尺寸750x400
根瘤菌试验图片
图片尺寸598x434
大豆根瘤菌长什么样一起来认识认识吧
图片尺寸449x800